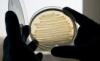
Это не научная фантастика. Группа исследователей из Эксетерского университета, работавшая при поддержке компании Shell, заставила бактерии E. coli (кишечная палочка) вырабатывать дизельное топливо.

Комментарии участников:
Да это шутка для begemoth-А. Спросите у путена завтра = раз вас так мандражит. Ну или в методичке у себя читайте ;) — приходят же по майлу?
зы. И да кажется коммерческие перспективы данного изобретения тут в комментариях раскрыты.
зы. И да кажется коммерческие перспективы данного изобретения тут в комментариях раскрыты.
Спросите у путена завтраПутин сам себя выбрал, сам себя и спрашивать будет.
Но если вы верите в честность выборов и Деда Мороза, можете попробовать спросить у него про тарифы Газпрома. Спорим на 100 госдеповских баксов и одну печеньку, что ваш вопрос не пройдет?
А зачем спрашивать? Достаточно знакомых в разных регионах РФ что бы знать что внутренние тарифы на газ относительно НЕ низкие. Вы за низкую цену на газ?
3,14ц «Газпрому»А мы над этим вместе посмеемся, когда Национальное Достояние будет «компенсировать выпадающие доходы» тарифами на внутреннем рынке.
на входе — сахара. не вижу принципиальной разницы с уже имеющимися сортами биотоплива. точно такой же перевод посевных площадей в солярку
Простите, но уже довольно давно снят научно-поулярный фильм «Клетка», где показано как бактерии с изменённым геномом синтезируют соляру. Так что на сенсацию не тянет…
пока получен только в лаборатории в мизерных количествах, но исследователи надеются, что разработанная ими технология сможет проложить себе путь к промышленному использованию.ждем, чо.
нам уже столько обещали снижения цен на топливо, нам не привыкать ждать годами :)
МОСКВА, 30 июл — РИА Новости. Американские ученые создали новый вид биотоплива, не отличающийся от обычного бензина, с помощью бактерий, перерабатывающих углеводы из различных типов промышленных и сельскохозяйственных отходов, стоимость такого «биобензина» может не превысить 50 долларов за баррель, сообщается в статье исследователей, опубликованной в журнале Science в четверг.11:25 30.07.2010
Группа разработчиков сумела с помощью методов генной инженерии «научить» безвредные бактерии E.coli вырабатывать несвойственный им тип химических соединений — так называемых насыщенных углеводородов или алканов. Именно алканы являются ключевым компонентом бензина, а потому такое биотопливо может быть сразу после получения отправлено в распределительные сети заправочных станций, существующие сегодня.
До сих пор для массового использования биотоплива, в частности, биодизельного, приходилось создавать специальные станции и трубопроводы для очистки и транспортировки, так как химический состав такого типа синтетического топлива отличается от природного.
Именно по этой причине уже не один год ученые искали способ наладить производство биотоплива, химически не отличающегося от получаемого на нефтеперерабатывающих заводах, однако первыми успеха достигла группа исследователей из инновационной компании LS9 в Сан-Франциско, США, занимающейся разработкой новых видов биотоплива.
В своей работе ученые использовали генетический материал микроорганизмов — так называемых цианобактерий, некоторые из которых способны вырабатывать алканы в ходе жизнедеятельности, основанной, как и у растений, на фотосинтезе. Изучив геномы 10 различных штаммов этих бактерий и сравнив их со штаммами бактерий, алканов не производящих, ученые сумели выявить 17 генов-кандидатов, которые могли быть вовлечены в биологический процесс производства алканов.
После этого исследователи отбросили из этого числа гены, функции которых уже были известны, и привили оставшиеся 2 бактериям E.coli. Как показали ученые в дальнейшем, их бактерии после генетического модифицирования действительно получили возможность синтезировать алканы.
«Таким образом, мы получили одностадийный процесс биологического синтеза алканов. Нам требуется только очистить сырье и получить из него питательные сахара для бактерий, и на следующем этапе мы получаем топливо, готовое для применения в транспортных средствах», — сказал ведущий автор публикации Андреас Ширмер (Andreas Schirmer), слова которого приводит интернет-издание New Scientist.
Авторы разработки отмечают, что их бактерии могут употреблять в пищу углеводы, полученные даже из скошенной травы или отходов переработки растительных продуктов, а потому производство такого биотоплива не увеличит спрос на возделываемые земли, и, соответственно, не приведет к повышению цен на продукты питания.
Пока что ученые сумели получить только 10 литров топлива в своем экспериментальном реакторе, однако исследователи уверены, что можно увеличить масштабы производства и добиться беспрерывного процесса получения биотоплива стоимостью не выше 50 долларов за баррель.
Это актуально для америки где:
1) Стригут газоны ( у нас это не привилось, но зато у нас много брошенных земель )
2) Выбрасывают еду которую не съели на ужин ( у нас тарят в холодильник и доедают ). Фактически там выбрасывают 50% еды
3) Нету коррупции и технологии быстро внедряются в массы
1) Стригут газоны ( у нас это не привилось, но зато у нас много брошенных земель )
2) Выбрасывают еду которую не съели на ужин ( у нас тарят в холодильник и доедают ). Фактически там выбрасывают 50% еды
3) Нету коррупции и технологии быстро внедряются в массы
кишечная палочка в промышленных масштабах :/ я далеко не параноик, но даже мне это не нравится) почему не на основе каких-нибудь молочнокислых, блин?
а вдруг «удачная» мутация?)
а вдруг «удачная» мутация?)
Если смотреть глубже, то двигатель внутреннего сгорания абсолютный анохранизм механистической эпохи. Делать для него биотопливо примерно тоже, что пристраивать к к Феликсу моторчик. Хотя я ещё работал на достижениях мировой (и нашей тоже) техники — механических вычислительных машинах. Диплом я частично считал на такой, а частично уже на электронном калькуляторе (размером с хороший чемодан).